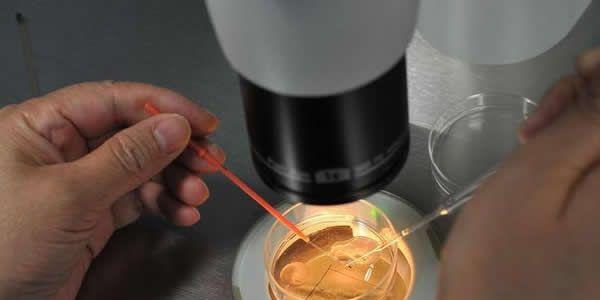

卵裂期胚胎和囊胚移植哪个好?一文让你了解清楚
- 试管婴儿
- 2025-01-11 09:16
在辅助助孕过程中,很多患者朋友们经常心中有疑惑:究竟移植卵裂期胚胎好,还是移植囊胚更好?下面我们就这个问题来谈一谈:卵裂期胚胎和囊胚移植哪个好?它们的区别在哪里?
一、卵裂期胚胎和囊胚移植的区别
卵裂期胚胎:精卵结合之后形成受精卵,受精卵经过细胞分裂形成不同阶段的胚胎。卵裂期胚胎是指发育到第3天的胚胎。精卵结合之后形成受精卵,受精卵经过细胞分裂形成不同阶段的胚胎。我们把取卵后第2~3天的胚胎称为卵裂期胚胎,卵裂期胚胎细胞数目较少,第二天的胚胎在4个细胞左右,第三天的胚胎在8个细胞左右。
囊胚:精卵结合之后形成受精卵,受精卵经过细胞分裂形成不同阶段的胚胎。胚胎发育到第5天和第6天是囊胚。而发育至第5~6天的胚胎,此时的胚胎细胞数较多,有数十个甚至上百个,在囊胚内部形成一个囊胚腔,细胞群分化成内细胞团和滋养层细胞,囊胚腔中央的一团称为内细胞团,周围的一圈细胞称为滋养层细胞。
二、卵裂期胚胎和囊胚移植哪个好
卵裂期胚移植的优点:卵裂期胚胎一般在取卵后第三天移植入宫腔内,与囊胚相比,它的体外培养时间更短,胚胎可以更早的回归母亲体内;此外,从卵裂期胚胎培养到囊胚阶段,囊胚的形成率大概60%左右,也就是说不是所有的卵裂期胚胎都能发育成囊胚,有一些发育潜能差的卵裂期胚胎会被淘汰,所以选择卵裂期胚胎移植可能有更多的移植机会,避免了无胚胎可移植的情况发生。
卵裂期胚移植的缺点:与囊胚相比卵裂期胚胎的种植率低。卵裂期胚胎的着床率在30-35%,囊胚的着床率可以到达50%以上。
囊胚移植的优点:囊胚的优势在于,它经过了更长时间的筛选,淘汰掉了一些质量差,发育潜能低的卵裂期胚胎,这种胚胎移植成功率也低,可以避免因为反复移植而浪费宝贵的时间和金钱。经过层层筛选,能形成囊胚的胚胎发育潜能更好,也更加优秀,移植后成功率也更高。其次,在自然情况下,精卵结合以及早期的胚胎发育是在输卵管内完成的,然后在宫腔内发育成囊胚,所以囊胚与子宫内膜容受性更加同步。
囊胚移植的缺点:由于体外培养条件的限制,即染色体正常的胚胎仍有可能无法发育到囊胚。囊胚移植的取消率明显更高,特别是卵子数量比较少的时候。
因此,实验室专家的经验和专业知识对于培育高质量胚胎和实现高妊娠率的试管婴儿治疗至关重要,实验室技术也直接决定胚胎培养和移植的成功率。
综上所述:这两个阶段的胚胎有各自的特点和优势,到底是选择移植卵裂期胚胎还是囊胚,医生需要根据每位患者的年龄、子宫内膜、胚胎数目以及胚胎质量等诸多因素制定最优的方案,才能取得最佳的治疗效果。

发表评论